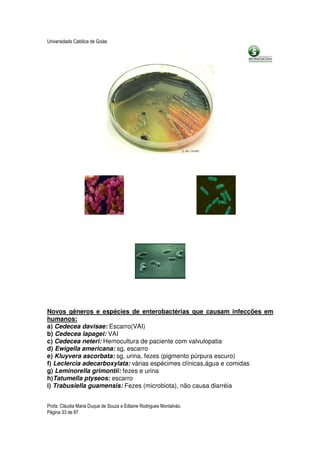
Universidade Católica de Goiás




Novos gêneros e espécies de enterobactérias que causam infeccões em
humanos:
a) Cedecea davisae: Escarro(VAI)
b) Cedecea lapagei: VAI
c) Cedecea neteri: Hemocultura de paciente com valvulopatia
d) Ewigella americana: sg, escarro
e) Kluyvera ascorbata: sg, urina, fezes (pigmento púrpura escuro)
f) Leclercia adecarboxylata: várias espécimes clínicas,água e comidas
g) Leminorella grimontii: fezes e urina
h)Tatumella ptyseos: escarro
i) Trabusiella guamensis: Fezes (microbiota), não causa diarréia


Profa. Cláudia Maria Duque de Souza e Edlaine Rodrigues Montalváo.
Página 33 de 87

1) O documento descreve um plano de disciplina de Microbiologia I para estudantes de Biomedicina. 2) O objetivo geral é demonstrar técnicas bacteriológicas e identificar gêneros, espécies e patologias de microrganismos. 3) Os objetivos específicos são habilitar os alunos para reconhecimento e diferenciação de microrganismos normais e patogênicos em diferentes partes do corpo humano.








![Universidade Católica de Goiás
cult da BBL® e o Coletor de amostras anaeróbicas da BD [tubo fechado e
saturado com gás].).
Sempre que possível coletar as amostras antes da administração de
antibióticos, a qual irá reduzir a segurança do resultado da cultura
(possibilidade de falso negativo), porém, existem microorganismos que têm o
seu crescimento normal mesmo em presença de antibióticos.
Há casos nos quais vários antibióticos da terapia têm ação bacteriostática e ,
quando colocamos a amostra em meios frescos (líquidos), com CIM
(concentração inibitória mínima) de antibióticos, abaixo da concentração
existente no local da infecção, o isolamento não fica problemático.
Para um bom desempenho dos exames bacteriológicos existem certas
regras de cadastramento do paciente que devem ser observadas:
O recipiente deve ser rotulado de maneira legível e contendo todas as
informações completas sobre o paciente, tais como:
# Numeração do exame;
# Médico;
# Data e hora;
#Local da coleta do material.
Deve-se ter um bom contato com o médico, no caso de precisar de
alguma informação antecipada do quadro do paciente.
TEMPO DE ENTREGA DAS AMOSTRAS:
1) Respiratória: 30 min
2) Gastrointestinal: 1h
3) Hemocultura: 30 min
4) Anaeróbio: 30 min
5) Catéter intravascular: 15 min
6) LCR e líquido pleural
7) Urina: até 1h, se refrigerada
8) Swabs: imediatamente
9) Amostras com anestésicos locais: Imediatamente!!
Profa. Cláudia Maria Duque de Souza e Edlaine Rodrigues Montalváo.
Página 9 de 87](https://image.slidesharecdn.com/apostilamicrobiologiai-130116061349-phpapp01/85/Apostila-microbiologia-i-9-320.jpg)















![Universidade Católica de Goiás
AULA 4
COPROCULTURA
Este exame é destinado a isolar os microrganismos causadores das
diarréias, disenterias purulentas, sanguinolentas e mucosas e dores abdominais.
As fezes podem se apresentar sólidas, líquidas ou pastosas;
normalmente, as fezes líquidas e pastosas são características de agentes
gastrointestinais patogênicos. Quando as fezes do paciente estão sólidas e ele
está apresentando dores abdominais, o médico pode administrar um laxante
para facilitar o trabalho da coprocultura; se as fezes estiverem líquidas ou
pastosas há necessidade de se fazer uma suspensão em salina estéril.
A semeadura é feita num caldo de enriquecimento, podendo ser utilizado
o caldo selenito, caldo tetrationato ou caldo GN, ou em meios seletivos (SS,
Hektoen, XLD [xilose lisina desoxicolato], ágar sulfito-bismuto, ágar
MacConckey, EMB ou ENDO).
As espécies que podem ser encontradas causando gastroenterites são:
Campylobacter pylori, Camppylobacter jejuni, Salmonella, spp; Shiguella, spp;
E. coli (enterotoxinogênica e enteropatogênica), Vibrio cholerae, Vibrio, spp;
Yersinia enterocolitica, Clostridium difficile e Staphylococcus aureus.
COLETA DE AMOSTRAS
Coletar em recipientes estéreis, de boca larga e que possam ser
hermeticamente fechados.
Para isolar Shiguella, spp e Neisseria gonorrhoeae, utilizar Swab retal,
sendo que para a N. gonorrhoeae tocar o Swab apenas no esfíncter anal tendo
o cuidado de não entrar em contato com as fezes.
Para o isolamento de bactérias patogênicas é bom colocar as fezes em
um conservante como o tampão fosfato de sódio ou potássio a 0,033 M mais
Profa. Cláudia Maria Duque de Souza e Edlaine Rodrigues Montalváo.
Página 25 de 87](https://image.slidesharecdn.com/apostilamicrobiologiai-130116061349-phpapp01/85/Apostila-microbiologia-i-25-320.jpg)